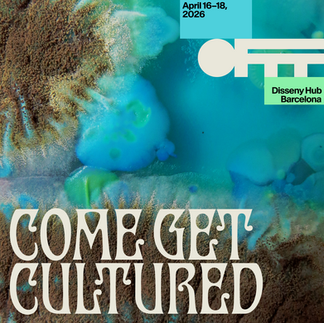
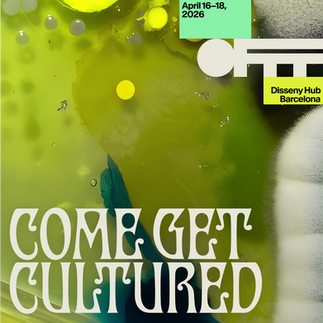

- Sep 27, 2023
- 1 min read
Updated: Mar 29
OFFF Barcelona – International festival of creativity, art and digital design
Upcoming edition: April 16-18, 2026 | Disseny Hub Barcelona
OFFF 2026 visual campaign 'Cultured' by Uncommon Creative Studio
This year, OFFF Barcelona has collaborated with Uncommon Creative Studio to develop the festival’s visual campaign, marking the official kick-off of the festival with a presentation by the studio’s co-founder, Nils Leonard. Titled 'Cultured', the campaign explores creativity as something shaped by the obsessive collection and curation of references, ideas, and perspectives drawn from a living, collaborative community. It reflects a simple belief: our industry is what we make it. Design is what we make it. Culture, too, is formed under the right conditions – through collaboration, shared agency, and intentional growth.
Together, OFFF and Uncommon are testing what happens when collaboration becomes the method, not the byproduct – when minds are mixed and new forms are grown collectively through conversation, experimentation, and determination.
'Cultured' is also an open invitation to the design community: come in, give yourself over, and play a part, because creativity is culture shaped by many rather than authored by a few.

OFFF 2025 aftermovie © LaviniaNext
OFFF 2025 images © Arnau Rovira
Contacts:
English-speaking media: Zoe Brooks, zoe@boopr.co.uk
Spanish-speaking media: Eva F. Cortés eva@fffea.com
OFFF: Elena Alekseeva, elena@offf.barcelona